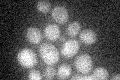
YIL146C
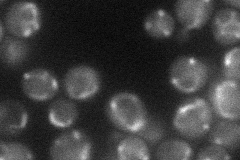
YIL146C
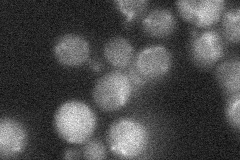
YIL146C
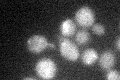
YIL146C
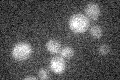
YIL146C

View description
Mitochondrial-anchored transmembrane receptor that interacts with the autophagy adaptor protein, Atg11p, and is essential for mitophagy, the selective vacuolar degradation of mitochondria in response to starvation
Localization:
Intensity:
Fold change:
Significance:
-
C’ GFP library in SD
below threshold17.73 -
N' NOP1pr-GFP in SD
mitochondria33.4642 -
N' TEF2pr-mCherry in SD

mitochondria0 -
N' NATIVEpr-GFP in SD
below threshold20.5473 -
N' TEF2pr-VC and Cyto-VN in SD

#N/A0 -
C’ GFP library in SD+DTT

cytosol17.260.97No -
C’ GFP library in SD+H2O2
cytosol18.761.05No -
C’ GFP library in Starvation Media
cytosol14.490.81No -
C’ GFP library on the background of Pup2-DaMP

below threshold -
C’ GFP library on the background of CCT mutant

below threshold18.16081.02378No
